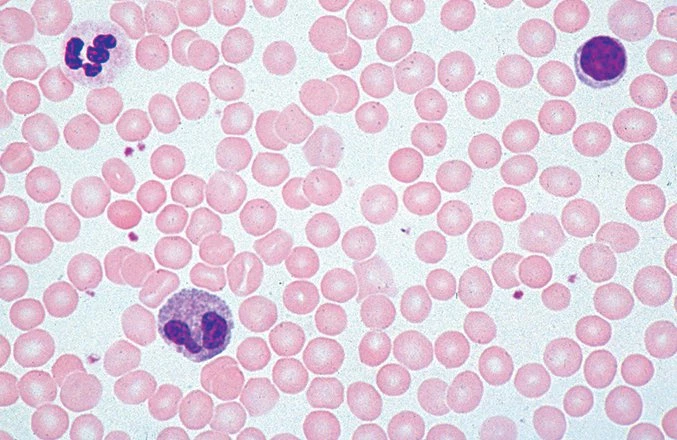
Flinn Scientific Basic Science Microscope For Kids & Students 7 Flinn Scientific Basic Science Microscope For Kids & Students - Image 7
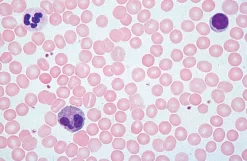
Flinn Scientific Basic Science Microscope For Kids & Students 13 Flinn Scientific Basic Science Microscope For Kids & Students -Learn and experiment ms1130 f

Product Details
Give students a microscope with all the functionality of the real thing at ž the size and â the price! Cordless operation allows the Flinn Basic Microscopes to go anywhere! Perfect for inspiring young scientists. Students view three-dimensional specimens using the top light and microscope slides using the bottom light.
Three objective lenses magnify from 40X to 400X when used with the included 10X eyepiece. Focusing is easy with one coarse focus knob. LED illumination is powered by three AA batteries or the included external power supply. Adjust the brightness using the disc diaphragm and keep slides in place with sturdy spring-loaded slide clips.
Features include:
⢠10X eyepiece
⢠4X, 10X and 40X objective lenses
⢠Coarse focus knob with adjustable rack stop and slip clutch protection
⢠LED illumination
⢠Cordless operation with batteries
⢠Sturdy, spring-loaded slide clips
⢠Includes dust cover, power supply and three AA batteries
⢠Two-year warranty
The 19th century was the golden age of microbiology, but the 21st century is the age of optical enhancement. If your microscopes would be considered classics if they were cars, it is time to take a look at new modern advancements! Allow your students to have a rich experience without fighting with sub-par microscopes. Consider replacing the microscopes in your lab for modern, easy-to-use options at affordable prices. At Flinn, we reimagined our microscopy line with your students in mind. Flinn Scientific developed this line of microscopes to give you all the most popular features at every price point. Buying microscopes is an investment, but in the rapidly changing world of science education, they remain an essential tool of the trade. Your future scientists will have the experience of a lifetime with Flinn microscopes! See more microscopes

Reviews
There are no reviews yet.